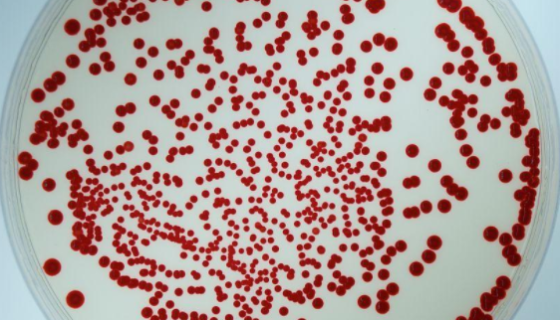
青枯雷尔氏菌的培养方法及冻干管打管说明！

出芽短梗霉菌的优势特点与功能功效及打管说明!
出芽短梗霉是Aureobasidium属的微生物,原产地为中...

唐菖蒲伯克霍尔德氏菌的培养与保存及注意事项!
唐菖蒲伯克霍尔德氏菌是Burkholderia属的微生物,原...

RHNC大鼠海马神经元细胞的培养步骤与操作说明!
大鼠海马神经元细胞分离自海马体;海马体(Hippocampu...

ATCC BAA-1293 纹带棒状杆菌 百欧博伟生物
纹带棒状杆菌是口腔内常见的定植菌,多形态,排列不规则,常呈栅...

柱状黄杆菌的形态特征与检测方法及注意事项!
柱状黄杆菌,病原英文名Flavobacterium clou...

HC11小鼠乳腺上皮细胞的处理方法与培养步骤!
HC11细胞株是COMMA-1D细胞的催乳素反应型克隆。它不...

ATCC 14174 杀鲑气单胞菌杀鲑亚种知识解析!
杀鲑气单胞菌杀鲑亚种是Aeromonas属的微生物,原产地为...
青枯雷尔氏菌的培养方法及冻干管打管说明!
青枯雷尔氏菌是Ralstonia属的微生物,原产地为中国。小...

HRMECs永生化人视网膜微血管内皮细胞的培养步骤!
人视网膜微血管内皮细胞分离自视网膜组织;视网膜居于眼球壁的内...